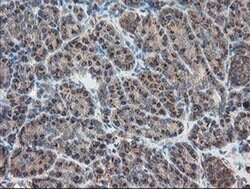
Invitrogen ACBD3 Monoclonal Antibody (OTI5F9) 100 &mu;L; Unconjugated:Antibodies,

missing translation for 'onlineSavingsMsg'
Learn More
Learn More
Invitrogen™ ACBD3 Monoclonal Antibody (OTI5F9)


Mouse Monoclonal Antibody
Brand: Invitrogen™ MA525999
This item is not returnable.
View return policy
Description
ACBD3 Monoclonal Antibody for Western Blot, IHC (P), Flow
GOLPH1, also known as GCP60, was initially identified as a Golgi protein that can interact with the integral membrane protein giantin and is thought to be involved in the maintenance of the Golgi structure. GOLPH1 has also been shown to interact with other Golgi proteins such as Golgin-160, a Golgi protein that can be cleaved by caspases-2, -3, and -7, leading to the nuclear localization of Golgin-160. GOLPH1 interaction with the Golgin-160 fragments is stronger than that with the intact Golgin-160, with its interaction regulated by the oxidation state of Cys-463 within GOLPH1, suggesting that the nuclear localization of the caspase-cleaved Golgin-160 fragments is a highly coordinated event. GOLPH1 has also been found to interact with Numb, a cytosolic signaling protein that mediates asymetric cell division of neural progenitor cells to a daughter progenitor cell and a neuron, suggesting that Golgi fragmentation and reconstitution during the cell cycle differentially regulate Numb signaling through changes in GOLPH1 subcellular distribution and may couple cell fate with cell cycle progression.
Specifications
| ACBD3 | |
| Monoclonal | |
| 1 mg/mL | |
| PBS with 1% BSA, 50% glycerol and 0.02% sodium azide; pH 7.3 | |
| Q9H3P7 | |
| Acbd3 | |
| Full length human recombinant protein of ACBD3 produced in HEK293T cell. | |
| 100 μL | |
| Primary | |
| Human | |
| Antibody | |
| IgG1 |
| Flow Cytometry, Immunohistochemistry (Paraffin), Western Blot | |
| OTI5F9 | |
| Unconjugated | |
| Acbd3 | |
| 60kDa; 8430407O11Rik; Acbd3; acyl-CoA binding domain containing 3; acyl-CoA-binding domain-containing protein 3; acyl-Coenzyme A binding domain containing 3; D1Ertd10e; DAP; DMT1-associated protein; fa20g08; GCP60; Gocap1; golgi complex associated protein 1, 60 kDa; golgi complex associated protein 1, 60kDa; golgi complex-associated protein 1; Golgi phosphoprotein 1; Golgi resident protein GCP60; Golgi resident protein GCP60, N-terminally processed; GOLPH1; neurotrophin receptor alike death domain protein; p75-like apoptosis-inducing death domain protein; Pap7; PBR- and PKA-associated protein 7; PBR associated protein; Peripheral benzodiazepine receptor-associated protein PAP7; peripherial benzodiazepine receptor associated protein; PKA (RIalpha)-associated protein; si:dkey-267p15.1; wu:fa20g08; zgc:66303 | |
| Mouse | |
| Affinity chromatography | |
| RUO | |
| 64746 | |
| -20°C, Avoid Freeze/Thaw Cycles | |
| Liquid |
Product Content Correction
Your input is important to us. Please complete this form to provide feedback related to the content on this product.
Product Title
Spot an opportunity for improvement?Share a Content Correction